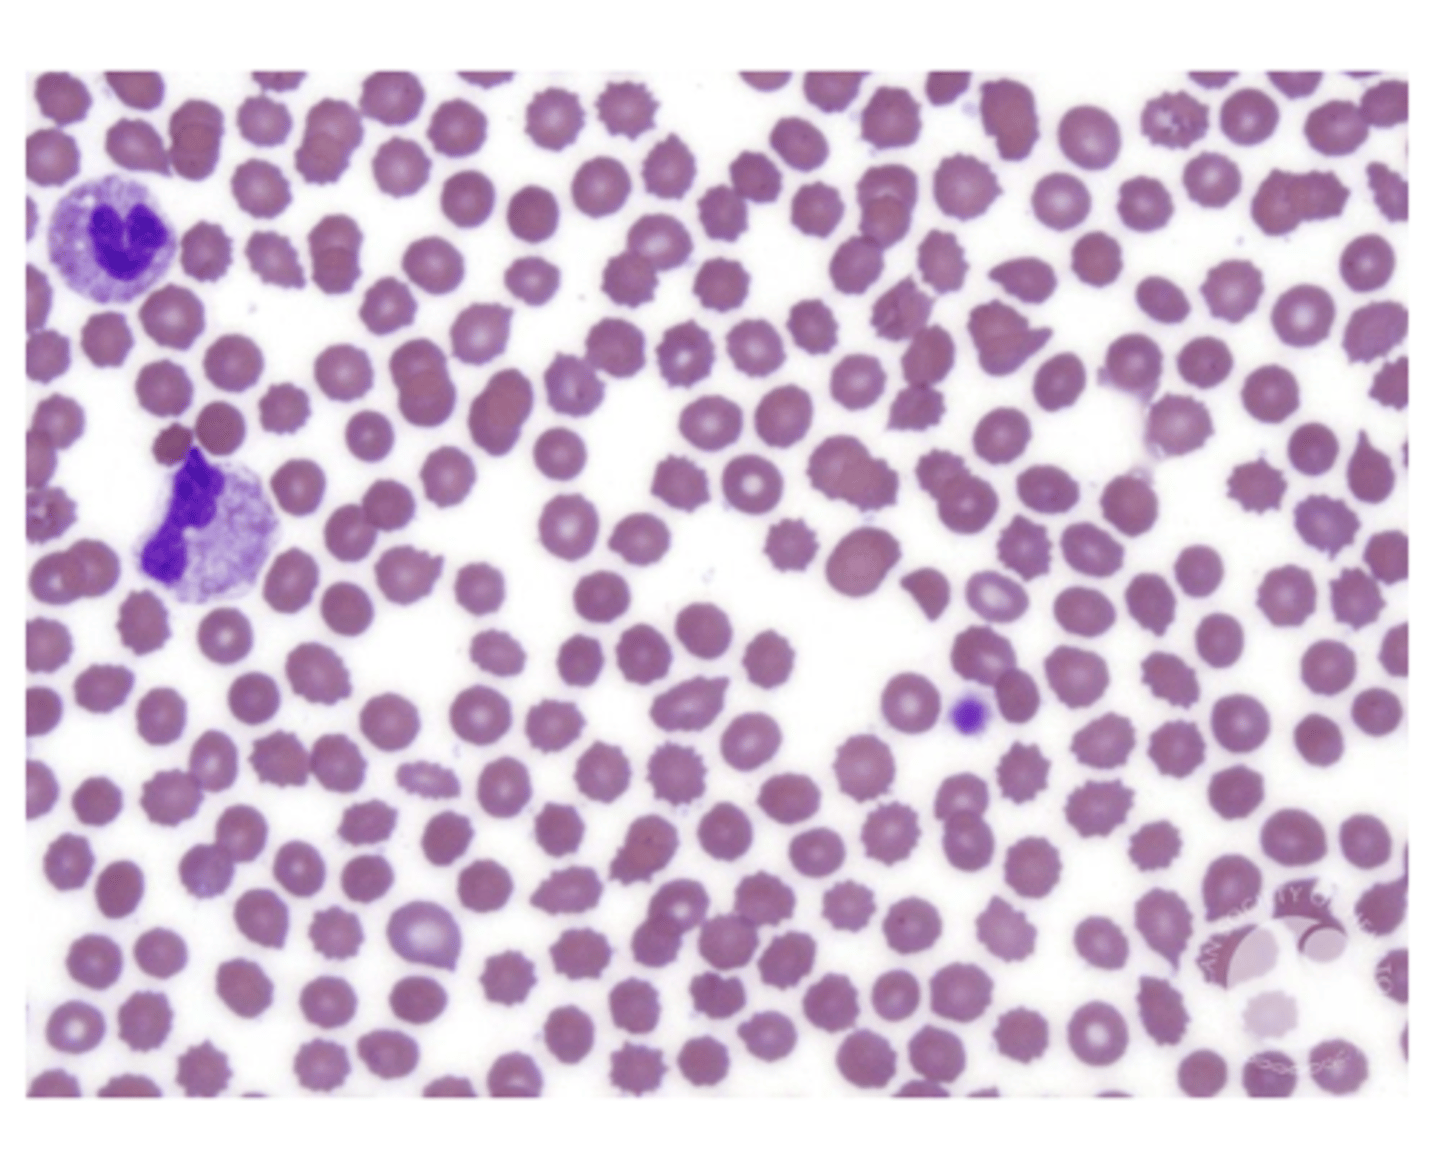
<p>CBC:</p><p>- anemia</p><p>- normo/normo</p><p>-PBS: echinocytes</p><p>UA:</p><p>- proteinuria</p><p>additional tests:</p><p>- kidney function test</p><p>- renal imaging studies</p><p>- nephrologist</p>
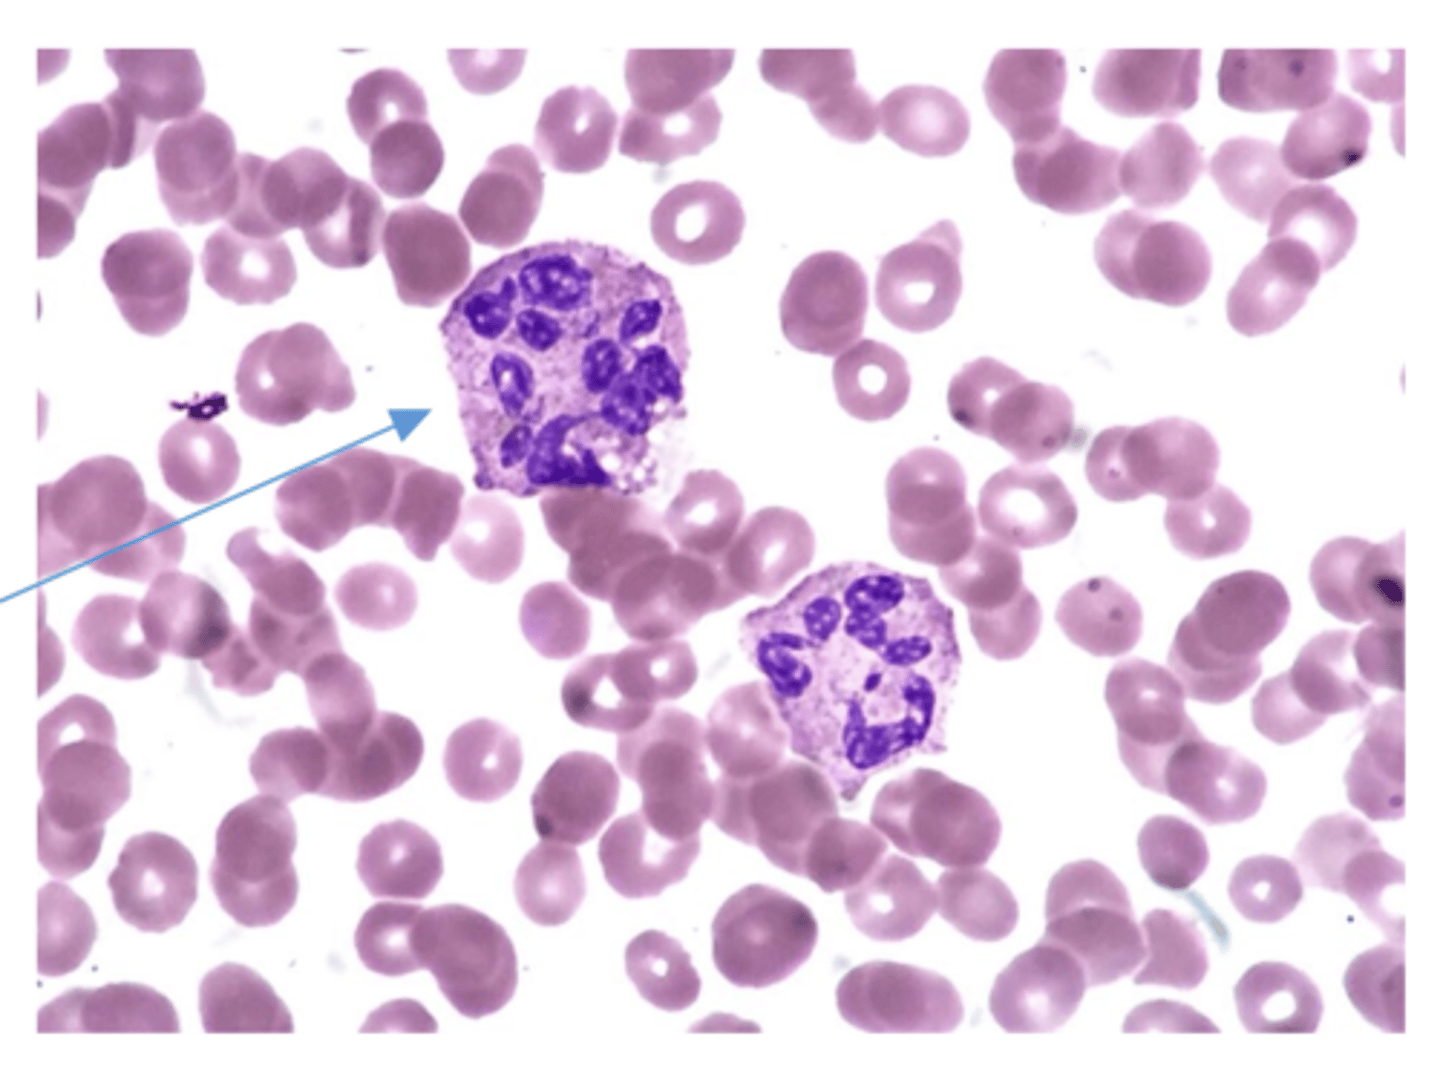
<p>B9/B12 anemia</p>

1/37
Looks like no tags are added yet.
Name | Mastery | Learn | Test | Matching | Spaced | Call with Kai |
|---|
No analytics yet
Send a link to your students to track their progress
anemia of renal disease is what type of anemia
an anemia d/t deficient erythropoiesis - normochromic-normocytic
_____ of anemia roughly parallels extent of renal dysfunction
• Chronic renal lesions in glomerular region à excretory failure
• Chronic kidney disease
Severity
• Anemia is usually _____ finding
• Renal insufficiency symptoms more _____
incidental
prominent
name some renal insufficiency symptoms
- edema
- hypertension
- fatigue
- decrease urine output
- increase frequency of urination
- muscle cramp
- weakness
anemia of renal disease lab findings
CBC:
UA:
additional tests:
CBC:
- anemia
- normo/normo
-PBS: echinocytes
UA:
- proteinuria
additional tests:
- kidney function test
- renal imaging studies
- nephrologist
management of anemia of renal disease
directed at underlying renal disease
anemia due to hypothyroidism is what type of anemia
Anemia d/t deficient erythropoiesis - normochromic-normocytic
anemia due to hypothyroidism
general

anemia due to hypothyroidism
clinical findings -
- related to primary disease
- fatigue
- brain fog
- increased sensitivity to cold
- constipation
- weight gain
- weakness
- thinning outer 1/3 of eyebrow
anemia due to hypothyroidism
CBC:
additional tests:
CBC:
- anemia
- hypo/micro
- normo/normo
- macro
additional tests:
- thyroid panel
- iron panel
- serum B12/RBC folate
anemia due to hypothyroidism
management -
hormonal therapy to correct primary disease will also stimulate production of more erythrocytes
- slower response to care
- endocrinologist
what type of anemia is aplastic anemia
Anemia d/t deficient erythropoiesis - normochromic-normocytic
aplastic anemia
general facts -
• Panhypoplasia
• Pancytopenia (decrease RBC, WBC, & plts) and hypocellular bone marrow (absence of abnormal cell infiltrate)
• Very severe
aplastic anemia
etiology -
• Idiopathic - most cases
• Drugs - 1/3 cases
• Viral (immunocompromised)
• Toxic exposures - glues, pesticides, insecticides
• Immune disorders
• Congenital (Fanconi anemia)
• Radiation treatment
aplastic anemia
clinical findings -
• Increased susceptibility to infections
• Hemorrhagic difficulties
• Pallor
• Fever
• Dyspnea
• Palpitations
aplastic anemia
CBC:
additional tests:
CBC:
- anemia (normo/normo)
- leukopenia; neutropenia
- thrombocytopenia
additional tests:
- low reticulocyte count
- bone marrow biopsy -> hypocellularity
aplastic anemia
management:
• Bone marrow transplantation
• Often refractory
Myelophthisic Anemia is what type of anemia
Anemia d/t deficient erythropoiesis - normochromic-normocytic
Myelophthisic Anemia
etiology -
• Carcinoma metastasizing to bone marrow from primary tumors
(breast, prostate, kidney, lung, adrenal, thyroid)
• Myelofibrosis - polycythemia vera
• Myeloproliferative conditions - Multiple myeloma, leukemias,
lymphoma, Hodgkin's
• Osteopetrosis
Myelophthisic Anemia
clinical findings -
• Symptoms of anemia
• Symptoms of underlying disease
• Hepatomegaly and splenomegaly
Myelophthisic Anemia
lab findings -
• Normochromic, normocytic anemia
• Nucleated RBCs
- teardrop RBC
• Immature WBCs
• Reticulocytosis, polychromatophilia
Myelophthisic Anemia
- management
• Directed toward underlying disease
Hypersegmentation of neutrophils indicates
B9/B12 anemia
Anemia due to Deficient Erythropoiesis - Megaloblastic/Macrocytic Anemia general facts -
• Defective DNA synthesis
• RNA synthesis continues
• All cell lines impacted
• Leukopenia
• Thrombocytopenia
Anemia due to vitamin B12 deficiency is what type of anemia
Anemia d/t deficient erythropoiesis - macrocytic/megaloblastic anemia
Anemia due to vitamin B12 deficiency
general facts -
• Synthesized by microorganisms - present in meat and other animal products
• Stored in liver - 5-6 years under healthy conditions
• B12 necessary for adequate DNA synthesis - folic acid metabolism
• Myelin synthesis
• Tissues which make new cells rapidly are most affected by deficiency of vitamin B12
Anemia due to vitamin B12 deficiency
etiology -
Deficiency of intrinsic factor
• Gastrectomy/gastric bypass (decrease IF -> decrease B12 absorption -> anemia)
• Myxedema
• Pernicious anemia (MCC B12 def.) (antibodies to IF & parietal cells)
Malabsorption Syndromes
• Celiac disease
• Crohn's disease
• SIBO
• Chronic pancreatitis or pancreatic cancer
Inadequate intake (strict vegans)
Anemia due to vitamin B12 deficiency
patient presentation -
Gastrointestinal
• Glossitis- sore tongue, beefy, red
• Weight loss (digestive issues)
• Anorexia
• Constipation w/ diarrhea
• Poorly localized abdominal pain
Neurological - MC
• May be present in absence of anemia
• Peripheral nerve involvement - most common
• Next - dorsal white column
• Vibratory sense
• Position sense
• Ataxia = difficulty walking
• Finally, spasticity, hyperactive reflexes, Babinski sign
Anemia due to vitamin B12 deficiency
PE findings -
Neuro Exam
• Position sense - decreased
• Vibration sense - decreased
• Abnormal reflexes
• Ataxia
• Babinski's sign +
• Extremity numbness, paresthesias
• Hypoalgesia "sock and glove"
• Poor finger coordination
• Romberg's sign +
• Vertigo
• Weakness
• Mental status changes
• Weight loss
• Glossitis
•Hepatomegaly/splenomegaly
• Skin pigmentation changes
• Anemia S/Sx
Anemia due to vitamin B12 deficiency
CBC:
PBS:
chem panel:
special tests:
CBC:
- anemia (macrocytic)
- increase RDW
- mild leukopenia
- mild thrombocytopenia
PBS:
- hyperhsegmented neutrophils
chem panel:
- increased serum bilirubin (unconjugated.)
special tests:
- decrease serum B12
- autoantibodies to IF & parietal
- increase MMA - borderline low serum B12
Anemia due to vitamin B12 deficiency
management -
• Emphasize meat, animal proteins
• Intramuscular B12 injections
• Oral B12 (cyanocobalamin & methylcobalamin) - 1,000-2,000 micrograms daily
• Hematologic correction - 6 weeks
• Neural improvement - up to 18 months
- retest B12 1-2 months (MMA) after treatment, if improvement retest 6-12 months
• PRECAUTION: folic acid treatment without B12 in patients with
pernicious anemia or B12 deficiency is contraindicated
-> severe and sudden neurologic symptom worsening
Anemia due to Folic Acid
Deficiency is what type of anemia
Anemia d/t deficient erythropoiesis - macrocytic/megaloblastic anemia
Anemia due to Folic Acid
Deficiency
general -
• Folic acid necessary for adequate synthesis of certain purines and
pyrimidines
DNA• Vegetables, yeast, liver, mushrooms
• Absorption: duodenum, jejunum
• Less liver storage
• Folic acid deficiency à macrocytic/megaloblastic anemia
- May look identical to B12 deficiency anemia on every lab except:
-- decrease RBC folate levels
*important for neural tube defect, CVD, cancer, cognitive functions
Anemia due to Folic Acid
Deficiency
etiology -
• Deficient dietary intake
• Tea and toasters
• Chronic alcoholics
• Chronic liver disease
• Increased requirements - pregnancy and lactation (MCC)
Anemia due to Folic Acid
Deficiency
clinical findings -
• Anemia symptoms - skin discoloration
• GI disturbances
• No neurological deficits ***
Anemia due to Folic Acid
Deficiency
CBC:
PBS:
special test:
CBC:
- same as B12
- anemia
PBS:
- hypersegmental - neutro/macro
special test:
*RBC folate
**if macro anemia: serum B12 & RBC folate
Anemia due to Folic Acid
Deficiency
management -
• Active folate (5-methyl-tetra-hydrofolate) - 400-1000 micrograms/day
- 1-3 months, retest RBC folate & CBC
- reticulocyte count @ 7-10 days
when pregnant what is the dosage for folate
400-800 mcg/day